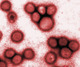
Snímek virusu chřipky.Zdroj: sherigambino.blogspot.com

Skrytá tvář infekčních onemocnění
 Pro účinný boj s nepřítelem, a hlavně s tím na život a na smrt, je potřeba znát ho stejně dobře jako se znáte sami. Infekce přitom mají mnoho různých podob - útočníkem může být hlavně virus, bakterie, parazit nebo houba. Houba je celkem jasná, paraziti jsou pro člověka prvoci nebo větší živočichové, bakterie jsou jednobuněčné organismy jednodušší než prvoci a viry jsou...zvláštní, ani živé, ani neživé. Na rozdíl od bakterií a vyšších organismů nepřežijí odkázané samy na sebe - potřebují hostitelskou buňku. Už na základě tohohle si můžete uvědomit třeba to, že dezinfekce vás například před viry vůbec nezachrání, protože ty jsou k nalezení téměř výhradně ve svých živých přenašečích a v jejich bezprostředním okolí. Abyste se úplně vyhli virové infekci, musíte se především úplně vyhnout nemocným lidem a zvířatům, stejně jako všem jejich čerstvým částem. Zamyslete se nad tím - to vůbec není jednoduché.
Pro účinný boj s nepřítelem, a hlavně s tím na život a na smrt, je potřeba znát ho stejně dobře jako se znáte sami. Infekce přitom mají mnoho různých podob - útočníkem může být hlavně virus, bakterie, parazit nebo houba. Houba je celkem jasná, paraziti jsou pro člověka prvoci nebo větší živočichové, bakterie jsou jednobuněčné organismy jednodušší než prvoci a viry jsou...zvláštní, ani živé, ani neživé. Na rozdíl od bakterií a vyšších organismů nepřežijí odkázané samy na sebe - potřebují hostitelskou buňku. Už na základě tohohle si můžete uvědomit třeba to, že dezinfekce vás například před viry vůbec nezachrání, protože ty jsou k nalezení téměř výhradně ve svých živých přenašečích a v jejich bezprostředním okolí. Abyste se úplně vyhli virové infekci, musíte se především úplně vyhnout nemocným lidem a zvířatům, stejně jako všem jejich čerstvým částem. Zamyslete se nad tím - to vůbec není jednoduché.
Prostředí a nositelé
 Svou domácnost pravděpodobně můžete být schopni uchránit před čímkoli, ale dříve nebo později budete muset buďto vylézt ven nebo pustit někoho nebo něco dovnitř. Ubránit se parazitům je v tomto smyslu například docela snadné - ti obvykle žijí v organickém odpadu nebo zkaženém jídle, případně je přenášejí různí škůdci. To platí do velké míry i o bakteriích a do nezanedbatelné míry také o virech a mykózách. Docela dobrým nápadem, když už tedy selže karanténa, je samozřejmě udržovat domácí prostředí čisté a škůdce hubit, stejně jako vyhýbat se nehygienickým podmínkám a škůdcům kdekoli jinde než doma. Mykózy si pak obzvlášť libují ve vlhkém prostředí a taková bažina patogeny všech druhů jenom kypí. Vydat se do takového prostředí je vyložený hazard, na který se dá jen těžko připravit. Snad jen několikanásobným očkováním, ale na to raději nespoléhejte.
Svou domácnost pravděpodobně můžete být schopni uchránit před čímkoli, ale dříve nebo později budete muset buďto vylézt ven nebo pustit někoho nebo něco dovnitř. Ubránit se parazitům je v tomto smyslu například docela snadné - ti obvykle žijí v organickém odpadu nebo zkaženém jídle, případně je přenášejí různí škůdci. To platí do velké míry i o bakteriích a do nezanedbatelné míry také o virech a mykózách. Docela dobrým nápadem, když už tedy selže karanténa, je samozřejmě udržovat domácí prostředí čisté a škůdce hubit, stejně jako vyhýbat se nehygienickým podmínkám a škůdcům kdekoli jinde než doma. Mykózy si pak obzvlášť libují ve vlhkém prostředí a taková bažina patogeny všech druhů jenom kypí. Vydat se do takového prostředí je vyložený hazard, na který se dá jen těžko připravit. Snad jen několikanásobným očkováním, ale na to raději nespoléhejte.
Nákaza v akci
 Infekce všech druhů pak mají několik základních klíčových ohledů, které rozhodují o tom, jak nakažlivé a smrtící budou - způsob přenosu (fyzickým kontaktem, tělesnými tekutinami, vzduchem), inkubační dobu (před propuknutím symptomů), viditelnost a smrtelnost symptomů spolu s rychlostí úmrtí a dobou trvání nemoci, rychlost reprodukce a tedy i evoluce patogenu a odolnost vůči různým druhům léčby. A teď, co byste řekli, že je nejnebezpečnější choroba Co takhle ebola, po které vám do týdne vykrvácí všechno všudy Ta třeba žádnou větší hrozbu nepředstavuje, protože příliš rychle zabije skoro všechny své přenašeče - takhle se nemůže šířit. Nebo že by HIV, které si sice dá na čas a nemá symptomy, ale nedá se vyléčit Ne, protože potřeba přenosu tělesných kapalin (a ještě ne všech) k nakažení je dost nešikovná - dá se jí velmi snadno předejít.
Infekce všech druhů pak mají několik základních klíčových ohledů, které rozhodují o tom, jak nakažlivé a smrtící budou - způsob přenosu (fyzickým kontaktem, tělesnými tekutinami, vzduchem), inkubační dobu (před propuknutím symptomů), viditelnost a smrtelnost symptomů spolu s rychlostí úmrtí a dobou trvání nemoci, rychlost reprodukce a tedy i evoluce patogenu a odolnost vůči různým druhům léčby. A teď, co byste řekli, že je nejnebezpečnější choroba Co takhle ebola, po které vám do týdne vykrvácí všechno všudy Ta třeba žádnou větší hrozbu nepředstavuje, protože příliš rychle zabije skoro všechny své přenašeče - takhle se nemůže šířit. Nebo že by HIV, které si sice dá na čas a nemá symptomy, ale nedá se vyléčit Ne, protože potřeba přenosu tělesných kapalin (a ještě ne všech) k nakažení je dost nešikovná - dá se jí velmi snadno předejít.
Myslete jako breberka
 Stejně tak ostatní "hrozné" infekce mají své achillovy paty - černé neštovice a vzteklinu vyřešilo očkování, protože nejsou dostatečně proměnlivé, aby obešly očkování. Bakteriální mor a cholera se dají relativně snadno porazit antibiotiky a těch pár meningokoků a streptokoků vyvíjejících rezistence je možné udržet pod kontrolou. Snad jen tuberkulóza vede opravdu tuhý boj proti moderní medicíně, ale na druhou stranu se rozvíjí a zabíjí jen velmi pomalu. Mykózy (houbové infekce) pak můžou být ve vzácných případech smrtelné, ale jen velmi těžko se šíří na velkých územích stejně jako parazitní prvoci, jeden z nichž způsobuje například spavou nemoc. Prvoci a houby mají také oproti bakteriím a hlavně virům velmi pomalý reprodukční cyklus, takže není tak překvapivé, že třeba proti malárii se začal relativně úspěšně evolucí přizpůsobovat naopak člověk - to je důvodem, proč někteří černoši trpí smrtelnou krevní poruchou s názvem srpkovitá anémie, přičemž jiní s její částečnou verzí žijí normálně úplně imunní vůči malárii.
Stejně tak ostatní "hrozné" infekce mají své achillovy paty - černé neštovice a vzteklinu vyřešilo očkování, protože nejsou dostatečně proměnlivé, aby obešly očkování. Bakteriální mor a cholera se dají relativně snadno porazit antibiotiky a těch pár meningokoků a streptokoků vyvíjejících rezistence je možné udržet pod kontrolou. Snad jen tuberkulóza vede opravdu tuhý boj proti moderní medicíně, ale na druhou stranu se rozvíjí a zabíjí jen velmi pomalu. Mykózy (houbové infekce) pak můžou být ve vzácných případech smrtelné, ale jen velmi těžko se šíří na velkých územích stejně jako parazitní prvoci, jeden z nichž způsobuje například spavou nemoc. Prvoci a houby mají také oproti bakteriím a hlavně virům velmi pomalý reprodukční cyklus, takže není tak překvapivé, že třeba proti malárii se začal relativně úspěšně evolucí přizpůsobovat naopak člověk - to je důvodem, proč někteří černoši trpí smrtelnou krevní poruchou s názvem srpkovitá anémie, přičemž jiní s její částečnou verzí žijí normálně úplně imunní vůči malárii.
A vítězem se stává...
 Možná jste si všimli, že jsem zatím jmenoval samé strašné choroby s náročnou, nebezpečnou nebo žádnou léčbou, navíc velmi smrtelné velmi nepříjemným způsobem, a zároveň je prohlásil za velmi málo nebezpečné. Opravdového vraha totiž z infekce dělají jiné, mnohem nenápadnější faktory - obecné a mírné symptomy v prvním stádiu, dlouhá inkubace, přenos vzduchem a rychlá mutace. Taková nemoc velmi rychle zamoří celou populaci než stačí pořádně zemřít jediný člověk a pak...už je pozdě. Jak se vyhnete někomu, na kom nepoznáte, že je nemocný Jak s ním můžet nedýchat stejný vzduch Co když nakažení lidé sami nebudou mít pocit, že jsou vážně nemocní, a tak nezůstanou doma a nepůjdou včas do nemocnice Samozřejmě to musí být virus, na který nezabere ani dezinfekce, ani antibiotika. Teď už by to mělo být jasné - vrahem číslo jedna mezi nemocemi se stamilióny obětí je pitomá chřipka, která už má na kontě několik pandemií. Očkování zastarává, prevence je nejistá, léčba zas vágní a symptomatická. Chcete-li ji přežít: zdravá strava, vzduch, pohyb a spánek, hodně tekutin, žádný stres, vitamín C a tak. Moderní medicína vám tu nepomůže, tak si hlavně nenechte nakecat opak - vytrénujte si zabijáka z vlastního imunitního systému.
Možná jste si všimli, že jsem zatím jmenoval samé strašné choroby s náročnou, nebezpečnou nebo žádnou léčbou, navíc velmi smrtelné velmi nepříjemným způsobem, a zároveň je prohlásil za velmi málo nebezpečné. Opravdového vraha totiž z infekce dělají jiné, mnohem nenápadnější faktory - obecné a mírné symptomy v prvním stádiu, dlouhá inkubace, přenos vzduchem a rychlá mutace. Taková nemoc velmi rychle zamoří celou populaci než stačí pořádně zemřít jediný člověk a pak...už je pozdě. Jak se vyhnete někomu, na kom nepoznáte, že je nemocný Jak s ním můžet nedýchat stejný vzduch Co když nakažení lidé sami nebudou mít pocit, že jsou vážně nemocní, a tak nezůstanou doma a nepůjdou včas do nemocnice Samozřejmě to musí být virus, na který nezabere ani dezinfekce, ani antibiotika. Teď už by to mělo být jasné - vrahem číslo jedna mezi nemocemi se stamilióny obětí je pitomá chřipka, která už má na kontě několik pandemií. Očkování zastarává, prevence je nejistá, léčba zas vágní a symptomatická. Chcete-li ji přežít: zdravá strava, vzduch, pohyb a spánek, hodně tekutin, žádný stres, vitamín C a tak. Moderní medicína vám tu nepomůže, tak si hlavně nenechte nakecat opak - vytrénujte si zabijáka z vlastního imunitního systému.

Diskuze